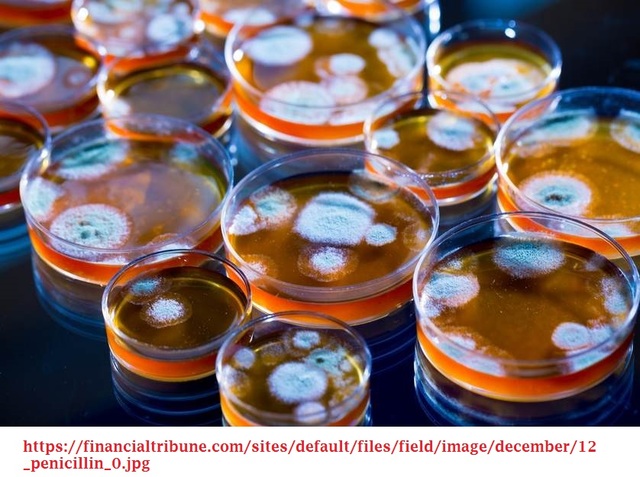
Penicilina, producción a nivel industrial

"La Ingeniería Química: Una Historia Rica y Diversa" (Autora: Irene Kim)---Alvarez Cirerol Gibran Gabriel
-
Antiguamente, en la época de la Edad Media, se realizaban algunas aleaciones,como la unión entre el cobre y el estaño.
-
Boyle establece su primer modelo de los ácidos y las bases, entre las que destacaba, que muchos de ellos reaccionan con metales, óxidos,hidróxidos, hidrogenocarboantos y carbonatos. Estas reacciones producen hidrógeno gas a diferentes velocidades según la reactividad del metal y la fuerza y concentración del ácido.
-
Toda la estructura de la Hidrodinámica de Daniel Bernoulli, en la que investiga gran cantidad de problemas teórico-prácticos, gira en torno a un tema central, que se conoce como el teorema que lleva su nombre. También desarrolló la teoría de la cinética de los gases, en la que las moléculas que los componen se mueven independientemente entre sí en todas las direcciones del espacio que ocupan, chocando de forma elástica unas con otras y contra las paredes del recipiente.
-
El azufre y el salitre se combinaron en un cucharón, se encendieron y se colocaron en una bandeja dentro de una cámara hecha de láminas de plomo ribeteadas, el piso del cual se cubrió con agua. Los gases de combustión se condensaron en las paredes y se absorbieron en el agua.
-
Considerado el primer texto de la química moderna, Lavoisier redacta sus descubrimientos más importantes, con la intención de dárselos a conocer a científicos de su época. Entre estos descubrimientos se encuentran descritos,ejemplo: su definición de "elemento" a las substancias puras, aquellas que no pueden descomponerse en unas más sencillas.
-
En sus orígenes se trataba de una manufactura de pólvora, pues había notado que el sector estaba mucho menos desarrollado que en Europa. Tan rápido creció la compañía que a mitad de Siglo ya era la mayor proveedora de pólvora del país. Durante la Guerra Civil en los Estados Unidos la compañía suministraba la mitad de la pólvora usada por el ejército de la Unión
-
Contribuyó a identificar experimentalmente por primera vez varios elementos químicos mediante la electrólisis y estudió la energía involucrada en el proceso, desarrolló la electroquímica explorando el uso de la pila de Volta o batería.
-
Demuestra que volúmenes iguales de todos los gases bajo las mismas condiciones de temperatura y presión contienen el mismo número de moléculas
-
Utilizó una torre de transferencia de masa para recuperar algunos de los nitratos, el ácido sulfúrico se escurría hacia abajo, mientras que los gases del quemador fluían. Parte del óxido nítrico fue absorbido por el gas, que fue devuelto a la cámara de plomo.
-
John Wesley Hyatt había desarrollado el celuloide, mientras buscaba un reemplazo para el marfil en bolas de billar.
-
Se dio acabo em Londres, con 360 miembros y como primer presidente, el químico Henry Roscoe.
-
GeorgeDavis ofrece conferencias sobre "operaciones químicas" (operaciones de la unidad) en la Escuela Técnica de Manchester(ETM).
-
Carl von Linde en 1895 licuó el aire a través de una serie de ciclos de compresión y expansión, el aire líquido se destiló en oxígeno y nitrógeno.
-
John Herreshoff desarrolla el primer método de contacto para ácido sulfúrico en EE. UU., el cual se basa en el empleo de un catalizador para convertir el SO2 en SO3, del que se obtiene ácido sulfúrico por hidratación.
-
Leo Hendrik Baekeland inventó la baquelita, un plástico hecho de fenol y formaldehido, mientras busca un reemplazo de goma laca.
-
William Burton, un químico de Standard Oil de Rocke Feller, comenzó a investigar formas de aumentar el rendimiento de la gasolina,tres años más tarde su equipo había desarrollado un método de destilación a presión para romper moléculas largas de hidrocarburos en las más pequeñas que componían gasolina. El proceso duplicó la cantidad de gasolina producida por cada barril de petróleo crudo y aumentó su índice de octanaje.
-
El proceso Haber-Bosch es un método catalítico de alta presión para producir amoníaco a partir de hidrógeno y nitrógeno, desarrollado por Fritz Haber en 1909 y ampliado por Karl Bosch unos años más tarde
-
En 1920, ·Standard Oil" abrió la primera planta petroquímica de los Estados Unidos
-
Eugene Houdry con catalizadores de sílice-alúmina, Houdry, un ingeniero mecánico francés, desarrolló por primera vez los catalizadores para producir gasolina a partir del carbón, y luego refinó el proceso para usar crudo de baja ley como materia prima.
-
El investigador Wallace Carothers, aisló cloropreno, un compuesto que se polimerizó para formar un sólido similar al caucho: neopreno.
-
El proceso Houdry, sin embargo, dio como resultado depósitos de coque en el catalizador, lo que requirió el apagado y la quema del coque. Warren K. Lewis y su antiguo alumno, el químico Eger VMurphree, se encontraban entre los investigadores que concibieron un método de lecho móvil, en el que el catalizador circularía entre un reactor y un regenerador. Fue Lewis y el ingeniero químico, Edwin Gilliland, quienes pensaron en usar un catalizador "fluidizado", que podría fluir a un regenerador.
-
La plataforma fue desarrollada por el ingeniero químico Vladimir Haensel, quien también quería eliminar los depósitos de coque en los catalizadores. Descubrió que a altas temperaturas, un catalizador de platino no solo impedía los depósitos de coque, sino que también producía gasolina con alto contenido de hidrógeno. El proceso también convirtió los naftenos en la materia prima en aromáticos, que previamente se habían producido a partir del carbón.
-
Pfizer, por ejemplo, adoptó un método de fermentación de tanque profundo que había estado usando para producir ácido cítrico a partir de melazas, Merck, para otro, desarrolló su propio proceso de fermentación sumergida. En junio de 1945, las firmas de Estados Unidos, incluidas estas y Abbott, Lederl e, y Squibb, producían 646 mil millones de unidades por mes.
-
en 1962, apareció un libro que iba a cambiar para siempre la forma en que la mayoría de los consumidores miraban las instituciones de ingenieros químicos. Silent Spring(Primavera Silenciosa), de la bióloga Rachel Carson, alertó a los lectores sobre el efecto del poderoso insecticida DDT(diclorodifeniltricloroetano, cierto insecticida de gran eficacia) en el medio ambiente.
-
Hacer los detergentes biodegradables, por ejemplo, fue la innovación del investigador de Monsanto James Roth,usó catalizadores de platino para producir moléculas de detergente que eran lineales y, por lo tanto, más digeribles por los microbios naturales en lagos y arroyos.
Plan projects on a visual timeline
Map milestones, phases, deadlines, and key events in one place so the sequence is easier to see and share. Timetoast is a timeline maker for work, school, research, and stories.